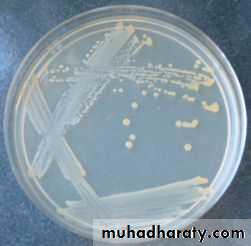
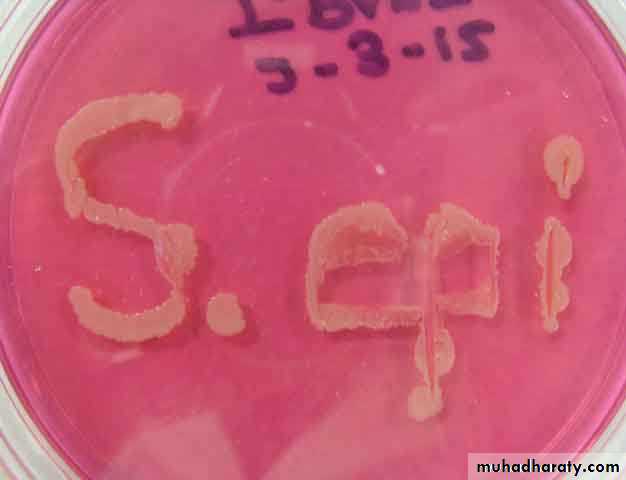

Human Microbial Flora
Dr. Waleed KhlaidLec. : 4
-They are a mixture of microorganisms regularly found at any anatomical site on /within the body of a healthy person.
Human microbial flora
-Normal flora include bacteria and fungi .
-Some of these microorganisms are found in association with humans / animals only. Others are found in the environment as well.
It is estimated that 500 to 1000 species of bacteria live in the human body .
Composition of normal flora depends upon many various factors including genetics, age, sex, stress, nutrition , antibiotics and diet
Although normal flora are found on all surfaces exposed to the environment (on the skin and eyes, in the mouth and nose), the vast majority of bacteria live in the large intestine.
-Symbiotic relationship means that normal flora derives a supply of nutrients, a stable environment, constant temperature, protection and transport from the host . On the other hand, the host obtains from the normal flora certain nutritional benefits, stimulation of the immune system, and colonization strategies that inhibit potential pathogens from occupying certain site.
Symbiotic relationship:
Symbiotic relationship
Resident floraConsists of relatively fixed types of microorganisms regularly found in a given area at a given age.
Transient flora
Consists of microorganisms that live in the skin or mucous membranes for hours, or days.Normal Microbial Flora Groups
-Normal flora are regularly
found in different anatomicalsites of human body .
The vast majority of bacteria
live in the large intestineDistribution of normal flora in human body
-Some body parts are normally occupied by normal flora , while other components and parts are normally devoid from any microorganism and its presence in these sites and components indicate that there is an infection. These sites and tissues are termed as sterile .
Examples of sterile tissues are:-
Blood - Brain- Muscle - Cerbrospinal fluid (CSF)
• 1-Skin
• 2-Head and respiratory tract• Eye, mouth, nasopharynx and ext. ear.
• Sterile sites: sinuses, middle ear,
• lower respiratory tract and lung
• 3-Gastrointestinal tract
• Esophagus, stomach, small intestine
• and large intestine
• 4-Genitourinary system
• Anterior urethra and vagina
• Sterile sites: cervix, uterus
Sites of human body that the normal flora microbes colonize
• Tissue tropism – one explanation of tissue tropism is that in one site the host provides an essential growth factors needed by the bacterium, while on the other sites the host may produce acids, bile salts and lysozymes making these sites not favourable for the microbial flora to live .
• Many of the normal flora are able to specifically colonize a particular tissue or surface using their own surface components like capsules, fimbriae, and cell wall components as specific tools for the attachment to specific receptors located at the colonization sites .
The explanations for why the normal bacterial flora are located at particular anatomical sites include:-
1.Immunostimulation
a) They produce antibodies which may contribute to host defenses.b) Some of these antibodies may cross react with normal tissue components (autoimmunity).
Significance of The Normal Flora (Advantages and Disadvantages)
2) Protection from External Invaders
-The normal flora occupy body’s epithelial surfaces, so they are able to prevent other pathogenic bacteria from establishing themselves by• Blocking receptors (attachment).
• Competing for essential nutrients.• C) Producing anti-bacterial substances e.g. fatty acids, peroxides and bacteriocines.
Normal Flora Competing With Invading Pathogens
3) Nutrition
-Some of the normal intestinal flora like E. coli & Bacteroids produce Vitamin K in the gut which is available for use by the host.4)Food metabolism
- They participate in food metabolismby producing proteolytic enzymes and
some substances that digest
carbohydrates .
5) Production of Carcinogens
-Some normal flora may modify, through their enzymes, some chemicals in our diets into carcinogense.g. artificial sweeteners may be enzymatically
modified into bladder carcinogens.6) Opportunistic infections
Normal flora may become a source of opportunistic infections , e.g. in-patients with impaired defense mechanisms.OPPORTUNISTIC INFECTION is an infection that is caused by an opportunistic pathogen which is a microorganism that is normally present as a commensal that does not harm its host but can cause disease when the host’s resistance is low .
opportunistic pathogens can cause disease in the following conditions:
a) When individuals become immunocompromised or debilitated.
b) When they change their usual anatomic location.
• Areas between the toes ( Toe webs )
1-Skin Flora
• Most common skin flora include :-
• Staphylococcus aureus,• Staphylococcus epidermidis
• Propionibacterium acnes
•
-Streptococci are the most common flora in the oral cavity specially Viridans group Streptococci ,one member of this group, Streptococcus mutans, is the etiological agent of dental caries.
-If they are introduced into the bloodstream, they have the potential of causing endocarditis, in particular in individuals with damaged heart valves. They are the most common causes of subacute bacterial endocarditis.
2-Oral Cavity Flora
-Many potential pathogens may be found in the nasopharynx of a healthy individual .
• Most common nasopharyngeal flora include :-• Streptococcus pneumoniae
• Neisseria meningitidis
• Haemophilus influenzae
3-Nasopharyngeal Flora
-The intestinal tract is another hostile environment for microorganisms.
-These organisms inhibit the growth of other pathogens but some can be opportunistic (e.g. Clostridium difficile that can produce pseudomembranous colitis) .4-Intestinal Flora
-The urogenital tract is normally sterile with the exception of the vagina and the distal 1 cm of the urethra
5-Urogenital Flora
Urethra :-It may contain predominantly skin microorganisms including staphylococci, streptococci and diphtheroids
-Vagina
The genus Lactobacillus predominate in the vagina,Lactobacillus generally lower the pH to around 4-5 which is optimal for the lactobacilli but inhibitory for the growth of many other bacteria.
Loss of this protective effect by antibiotic therapy can lead to infection by Candida ("yeast infection")